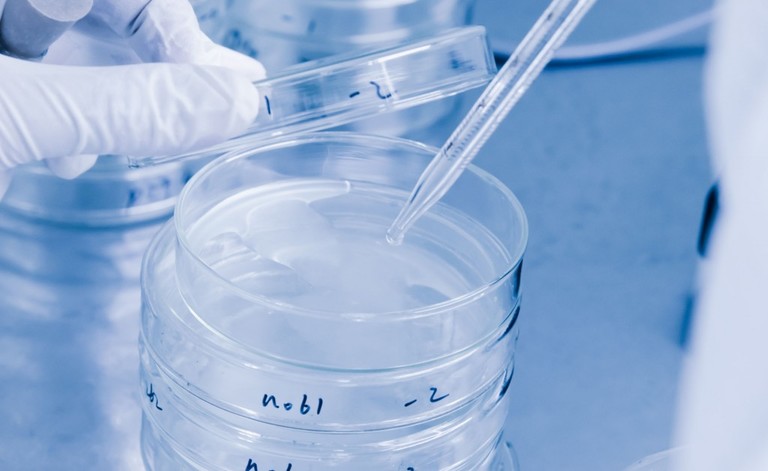
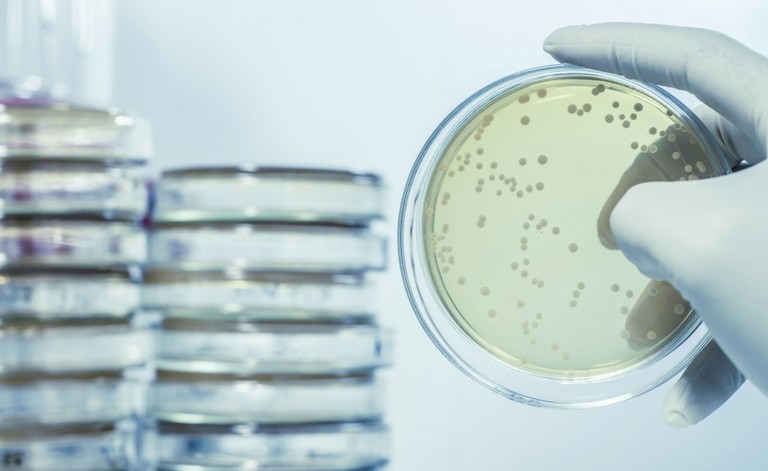

Cosa si nasconde dietro la dicitura “gluten-free”? È sempre bene leggere l’etichetta di ciò che si porta sulle proprie tavole. Scoprite perché.
Il 90% delle donne che sviluppano un cancro al seno hanno un’aspettativa di vita normale. Ma perché la minaccia può tornare?
A Milano è iniziata una campagna che promuove l’allattamento al seno e la sua importanza per mamme e figli.
Il pisolino pomeridiano sembra davvero avere dei benefici sulle nostre performance lavorative
Si chiama Zain il primo bambino nato grazie alla fecondazione in vitro facilitata dalle cellule staminali.
Un uso prolungato di Facebook può farci sentire tristi, soprattutto quando confrontiamo le nostre vite con quelle degli altri.
Conoscere le reazioni alle punture d’insetto è importante per capire quando intervenire e come.
Il trauma cranico sembra attenuare gli effetti del PTSD nei soggetti che hanno subito gravi incidenti o violenze.
Acqua e limone: un metodo tradizionale ma dagli enormi benefici per la nostra salute. Eccone 10 a cui non potrete resistere.
Il teratoma è la formazione di un altro organismo all’interno del nostro corpo. Ecco cosa è successo ad una ragazza indiana.
I frutti del Prunus trigno, tipico del Molise, hanno importanti proprietà antitumorali. Lo ha dimostrato uno studio.
Le immunodeficienze primitive sono causa di patologie spesso confuse con comuni infezioni. Ecco perché è necessaria la diagnosi precoce.